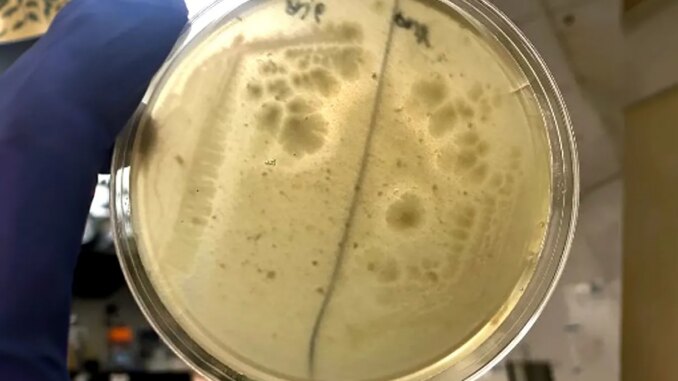

Researchers from IIS Princesa and McMaster University have identified a bacteria naturally present in the mouth that influences allergic responses and could be useful in mitigating food-induced anaphylaxis. Read
Source
Researchers from IIS Princesa and McMaster University have identified a bacteria naturally present in the mouth that influences allergic responses and could be useful in mitigating food-induced anaphylaxis. Read
Source
Copyright © 2026 | WordPress Theme by MH Themes
Leave a Reply